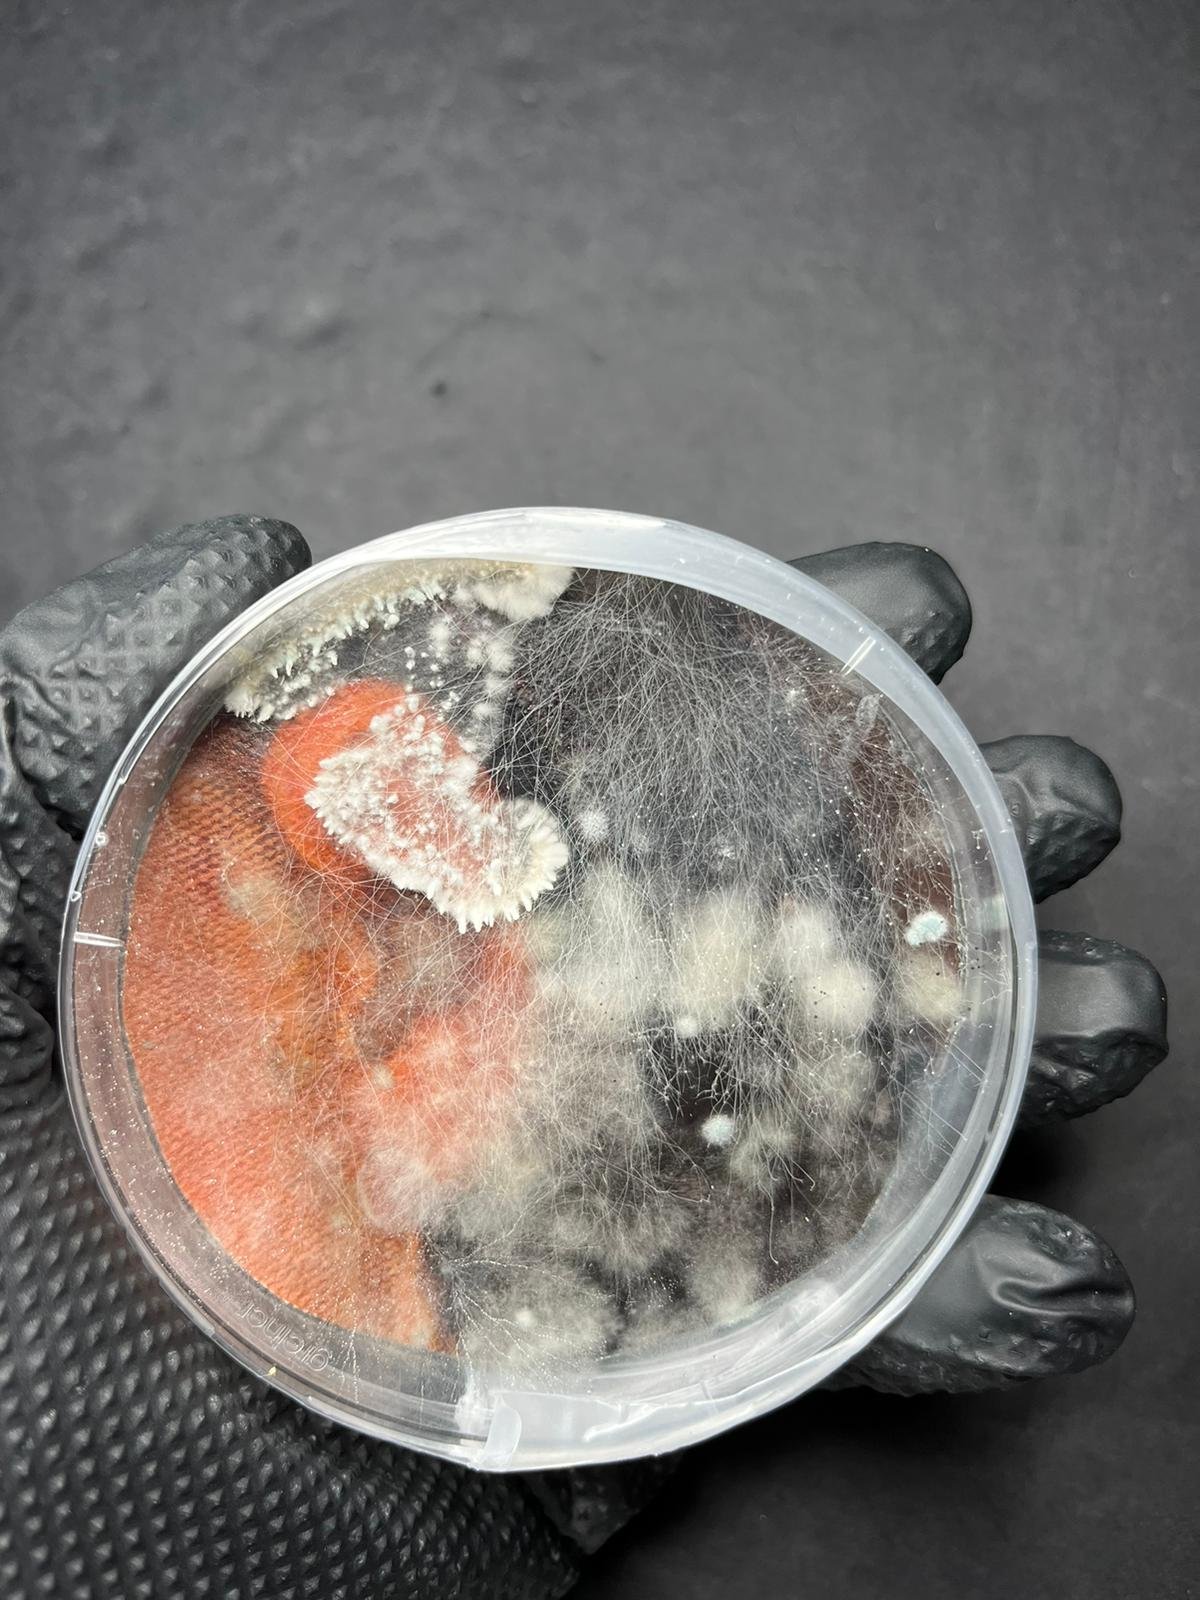

„Mokslas ir menas visada žingsniuoja greta. Manau, kad didžioji dalis gražiausio meno slypi moksliniuose tyrimuose ar tiesiog pasaulio stebėjime“, – sako mikologas dr. Patrickas Hickey, kuris įamžino kino žiūrovus sužavėjusius mikroskopinius pelėsinius grybus šiuo metu Lietuvos kino teatruose rodomame Aistės Žegulytės filme „Dulkės, kaulai ir stebuklai“.
Pasaulyje tėra keli operatoriai, kurie specializuojasi mikroskopinių grybų filmavime. Vienas iš jų – Škotijos sostinėje Edinburge gyvenantis mokslininkas P. Hickey, daugiau nei 25 metus tyrinėjantis ir fiksuojantis grybines kultūras. Jo filmuotų vaizdų galima pamatyti ir 2007 m. filme apie aplinkosaugą „11-oji valanda“, kurį kūrė Holivudo žvaigždė Leonardo di Caprio.
„Man A. Žegulytės filmas artimas ir toks asmeniškas ne tik dėl mylimų grybų, bet ir dėl pirmųjų filmo kadrų, kuriuose vaizduojamos beveik šimtmetį menančios akimirkos iš mano šeimos archyvo. Kai kurių asmenų net nesu sutikęs, kai kuriuos prisiminiau žiūrėdamas filmą. Tad peržiūros metu ne kartą kaupėsi ašaros“, – prisipažįsta Amsterdamo kino festivalyje filmą matęs P. Hickey.

Ne tik įrašo duomenis, bet ir atskleidžia grybų emocijas
Škotijos mokslininkas prisijungė prie filmo jau po pirmojo režisierės A. Žegulytės laiško – jam patiko filmo idėja, be to, apie grybus iki šiol žinoma nedaug, o tai pasirodė puiki proga platesnei visuomenei parodyti grybines kultūras, apie kurių egzistavimą ir įspūdingą pavidalą daugelis net nesusimąsto.
„Man patinka filmuoti iš meninės perspektyvos – ne tik įrašyti duomenis, kurie dažniausiai būna nespalvoti, tačiau ir atskleisti grybų emocijas, augimo judesius ir visą grožį, matomą tik pro mikroskopą“, – sako P. Hickey.
Režisierė su mokslininku keletą mėnesių eksperimentavo ir tyrinėjo, kurios grybų rūšys efektingiausiai ir paveikiausiai atsiskleistų didžiajame ekrane. Galiausiai pasirinko keturias pelėsinių grybų rūšis, kurios ir tapo pagrindiniais filmo herojais – su savotiškais charakteriais, kuriuos išryškino kompozitoriaus Gedimino Jakubkos muzikinės kompozicijos.
Tai erotiškasis Rhizopus stolonifer, šviesos bijantis Penicillium vulpinum, žmogiško smalsumo kupinas Pilobollus cristalinus bei mirtį nešantis Aspergillus niger. Kai kurių grybų sporų mokslininkas neturėjo, tad jos keliavo iš Lietuvos, Gamtos tyrimų centro Biodestruktorių tyrimų laboratorijos, specialiame siuntinyje su pasais.

Pelėsinio grybo sporą „apgyvendino“ braškėje
Pasak P. Hickey, kuriant filmą iššūkių būta daug, pavyzdžiui, vienų grybų gyvavimo ciklas trunka vos 24 valandas, kitų ir 4–7 paras.
„Kai kuriems grybams reikia daugiau šviesos, kad spalva taptų sodresne, bet studijos apšvietimas yra per ryškus. Kiti negali pakęsti šviesos ir gali sudygti tik patamsyje. Arba auga ilgi ir plaukuoti, daug juda, tad sudėtinga patraukliai juos užfiksuoti“, – pasakoja vienas iš filmo „Dulkės, kaulai ir stebuklai“ kūrėjų.
Mikroskopiniai grybai buvo filmuojami mokslininko P. Hickey laboratorijoje, dažniausiai įrengtoje didžiulėje juodoje dėžėje, kur buvo ruošiama visa scenografija ir kompiuterio ekrane stebimas grybų augimas. Grybai buvo fotografuojami, o vėliau, jungiant nuotraukų seką, kuriamas judantis vaizdas. Be to, buvo naudojamas tik steroskopinis mikroskopas, nes kūrėjams buvo svarbi natūraliai krentanti šviesa. Vien eksperimentiniai grybų filmavimai užtruko dvejus metus, vėliau sekė dar ketveri tikslingo filmavimo metai.
Škotų mokslininkas prisimena, kad vienas fantastiškas epizodas, kuriame pelėsinis grybas pasiglemžia braškę, buvo filmuojamas žiemą. Teko gerokai paieškoti šviežiai atrodančių uogų. „Mums reikėjo kad braškė natūraliai supelytų, tad joje „apgyvendinome“ grybų sporas. Žinoma, reikėjo ne vieno bandymo, šiam filmavimui sunaudojome kelis kilogramus braškių, kol užfiksavome tokį procesą, kokį ir įsivaizdavome“, – šypsosi mikologas.
Filmas priminė, koks trumpas mūsų gyvenimas
Pasak P. Hickey, „Dulkės, kaulai ir stebuklai“ – ne vien apie pelėsinius grybus, nors jie filme atlieka spalvingiausią vaidmenį.
„Tai tarsi žvilgsnis į laiką ir priminimas, koks trumpas yra mūsų gyvenimas. Filme rodomuose meno kūriniuose vaizduojami žmonės man leido suvokti, kad per šimtmečius mes nė kiek nepasikeitėme, kaip ir pelėsiniai grybai, kurie gyvuoja šimtus tūkstančių metų. Mes gimstame, einame į bažnyčią, krikštijamės, gyvename, mirštame, esame palaidojami. O grybai tiesiog kantriai laukia, kol įvyks kitas žmogaus gyvenimo ciklas“, – pastebi mokslininkas.
Apie tai, kas amžina ir kas laikina A. Žegulytės meninės dokumentikos filme „Dulkės, kaulai ir stebuklai“, kuris jau rodomas kino teatruose.
Filmą „Dulkės, kaulai ir stebuklai“ platina „Lokys, liūtas ir šakelė“, prodiuseriai – lietuvių „Studio Uljana Kim“ kartu su Prancūzijos kompanija „To Be Continued“ ir latvių „Studio Locomotive“. Filmo gamybą finansavo Lietuvos kino centras, Prancūzijos nacionalinis kino centras CNC, Latvijos nacionalinis kino centras bei Lietuvos nacionalinis radijas ir televizija. Filmo viešinimą dalinai finansuoja Lietuvos kino centras.
Filmo anonsas:


